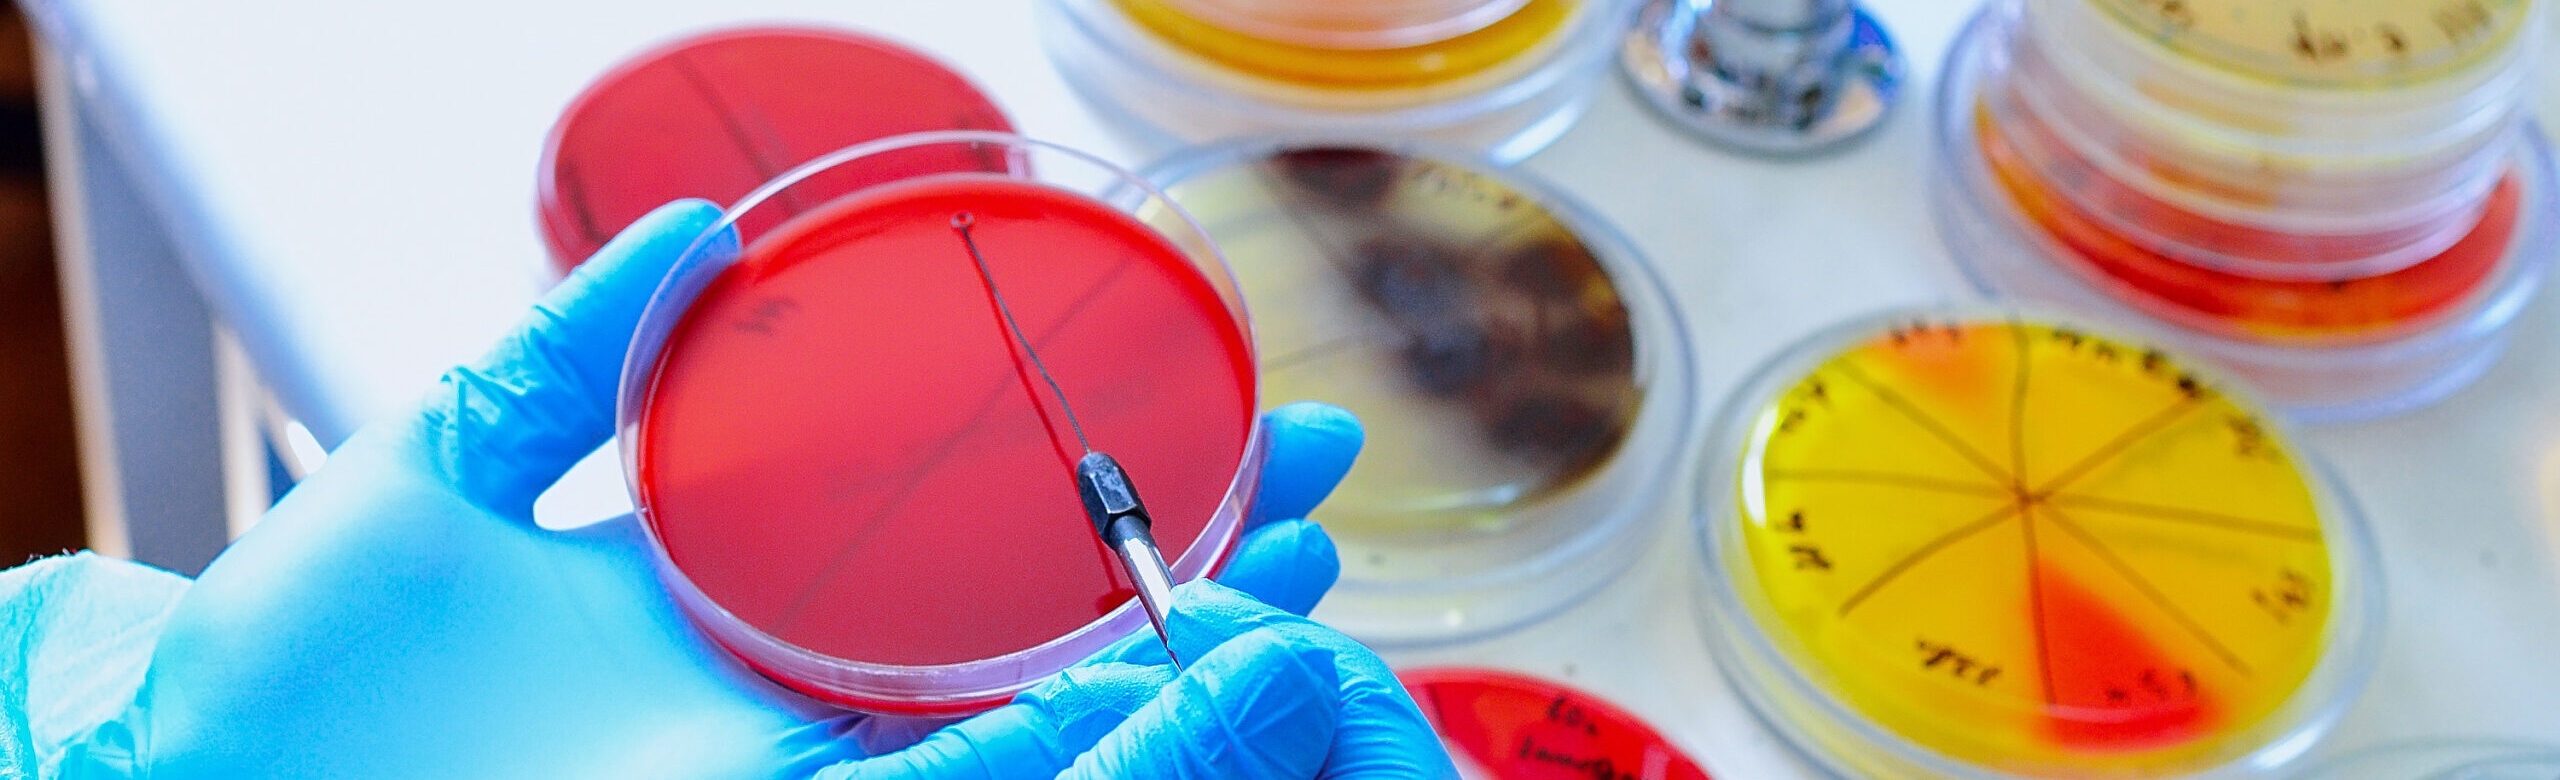

次世代につなげる感染症学・微生物学
杜の都医学振興財団は、感染症学および微生物学に関する研究・活動への
助成を通じて、将来の適切な感染症治療および感染症対策に貢献していきます。
また、奨学支援事業を通じて未来の医療を支える人材を応援し、
国民の健康と社会福祉の向上に寄与することを目指しています。
次世代につなげる感染症学・微生物学
杜の都医学振興財団は、感染症学および微生物学に
関する研究・活動への助成を通じて、
将来の適切な感染症治療および感染症対策に
貢献していきます。
また、奨学支援事業を通じて未来の医療を支える
人材を応援し、国民の健康と社会福祉の向上に
寄与することを目指しています。
事業内容
事業内容
お知らせ
2025年10月1日
2025年7月6日
2025年7月6日